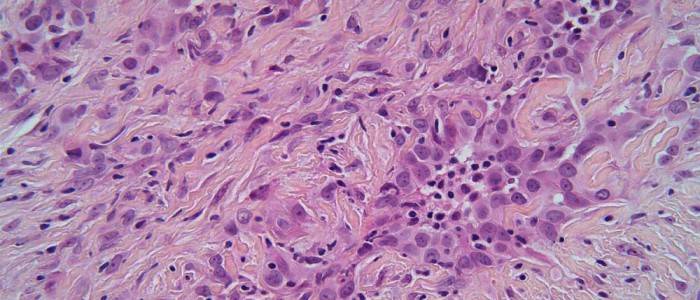

苏格兰“长期而痛苦”的石棉遗留问题将通过向格拉斯哥大学提供 210 万英镑的英国癌症研究基金来解决,旨在解决为什么接触这种纤维矿物需要数十年才能发展成癌症。
目前存活率非常低的间皮瘤最常见于覆盖肺部的组织层,通常是在吸入石棉纤维之后,并且可能需要 40 多年才能发展。
英国癌症研究中心已向格拉斯哥和剑桥的一组研究人员提供了 210 万英镑,以帮助解开从最初接触石棉到诊断之间的几十年中发生了什么问题的答案。
在格拉斯哥英国比森癌症研究所和格拉斯哥大学的 Daniel Murphy 教授以及剑桥医学研究委员会的 Marion MacFarlane 教授的带领下,他们希望找到新的分子特征,从而更容易更早地诊断和治疗间皮瘤 , 在出现症状之前。
胸痛、疲劳和持续咳嗽等早期症状可以被忽视,因为它们与其他疾病相似
根据英国癌症研究中心的数据,英国目前是世界上间皮瘤发病率最高的国家,由于与职业相关的接触,这种疾病在男性中更为普遍,苏格兰西海岸的发病率明显高于苏格兰平均水平,约为 100 该地区每年苏格兰有 200 例新病例。
1950 年至 1980 年间,石棉在工业上得到广泛使用,特别是在格拉斯哥及周边地区,因为这种材料是在克莱德班克等城镇制造的,并用于许多重工业,例如克莱德河闻名的造船业。
虽然这种材料现在已被取缔,但自 1990 年代初以来,间皮瘤病例有所增加。
位于格拉斯哥的英国比森癌症研究所和格拉斯哥大学的丹尼尔墨菲教授说:“石棉暴露给格拉斯哥和苏格兰西海岸蒙上了阴影,这里的间皮瘤发病率明显高于苏格兰平均水平。”
“间皮瘤很难治疗,对于那些被诊断出的人来说,结果通常很差。 为了制定预防和治疗间皮瘤的新策略,我们需要更深入地了解其进展背后的基础生物学。”
“这个名为 REMIT 的新计划将建立在英国癌症研究中心之前为世界领先的格拉斯哥领导项目 PREDICT-Meso 和 IAMMED-Meso 提供的大量资金的基础上,这些项目旨在为癌前肺患者定义高风险指标 可能发展为癌症的异常。”
“REMIT、IAMMED-Meso 和 PREDICT-Meso 现在将共同形成一个综合战略,用于间皮瘤患者的早期检测、风险分层和更有效的治疗。”
在苏格兰被诊断患有间皮瘤的人中,只有大约十分之四 (44.3%) 能存活一年或更长时间 (2015-2019)。
英国癌症研究中心研究与创新执行主任伊恩·福克斯博士说:“近半个世纪前,英国癌症研究中心的科学家们进一步了解了石棉的危险性。 这项研究帮助改变了健康和安全法规,减少了工人接触这种致命物质的机会。”
“在过去的二十年里,英国癌症研究中心资助的研究在治疗间皮瘤方面取得了进展。 由于研究人员的辛勤工作和我们支持者的慷慨解囊,利用免疫系统攻击间皮瘤的新疗法正在问世。”
“但今天仍然可悲地感受到石棉使用的长期和痛苦的遗产。 生存率仍然很低,我们需要更好的方法来及早发现间皮瘤。 这就是为什么我们正在资助更多的研究,以加深我们对这种疾病的了解,并为患者带来更大的改变。”
剑桥医学研究委员会毒理学部副主任 Marion MacFarlane 教授说:“间皮瘤对传统疗法没有反应,驱动它的突变不容易被药物靶向。”
“由于从最初接触到诊断之间的时间很长,而且很难区分癌前组织和良性组织,因此人们对早期疾病的分子特征知之甚少。”
注:本文由院校官方新闻直译,仅供参考,不代表指南留学态度观点。








